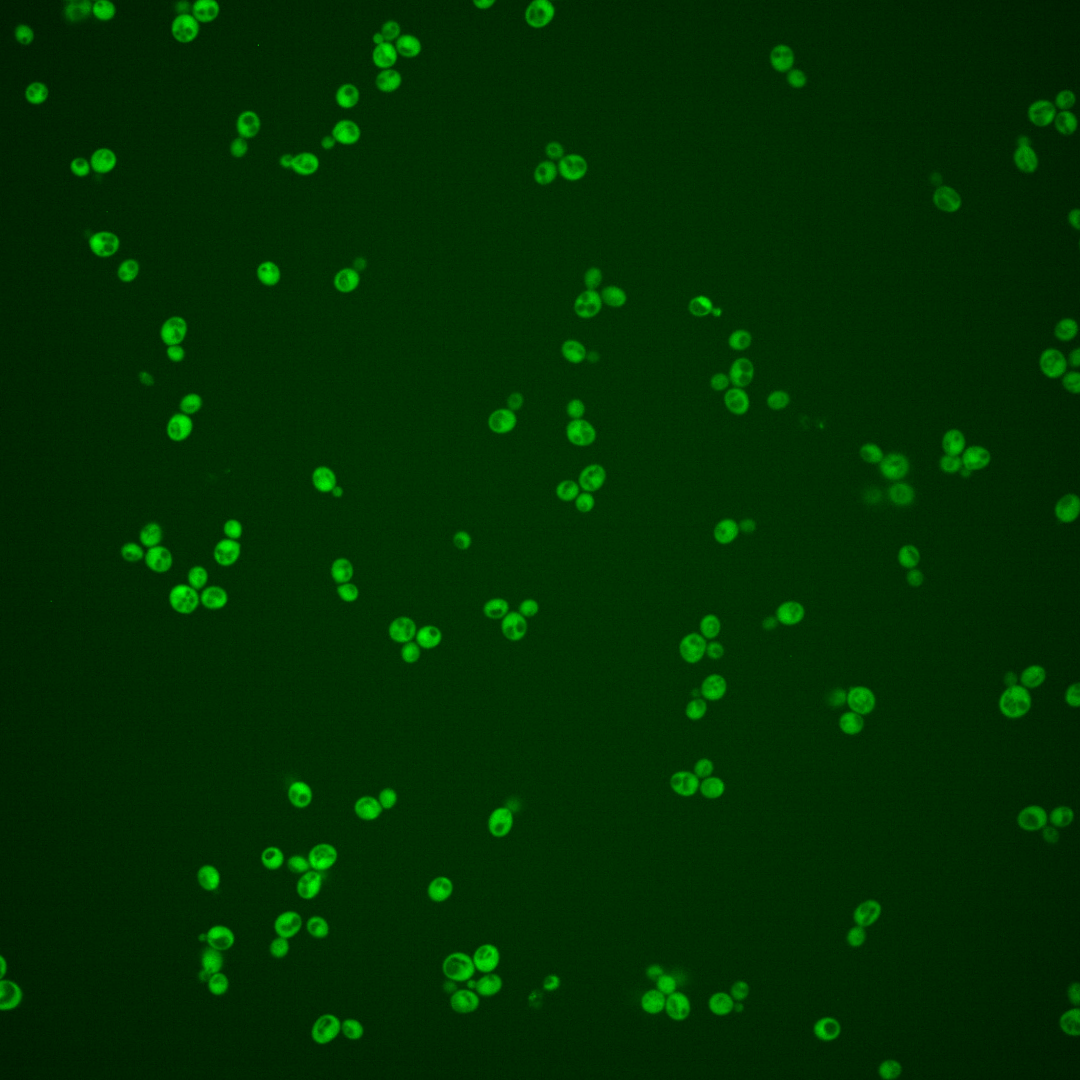
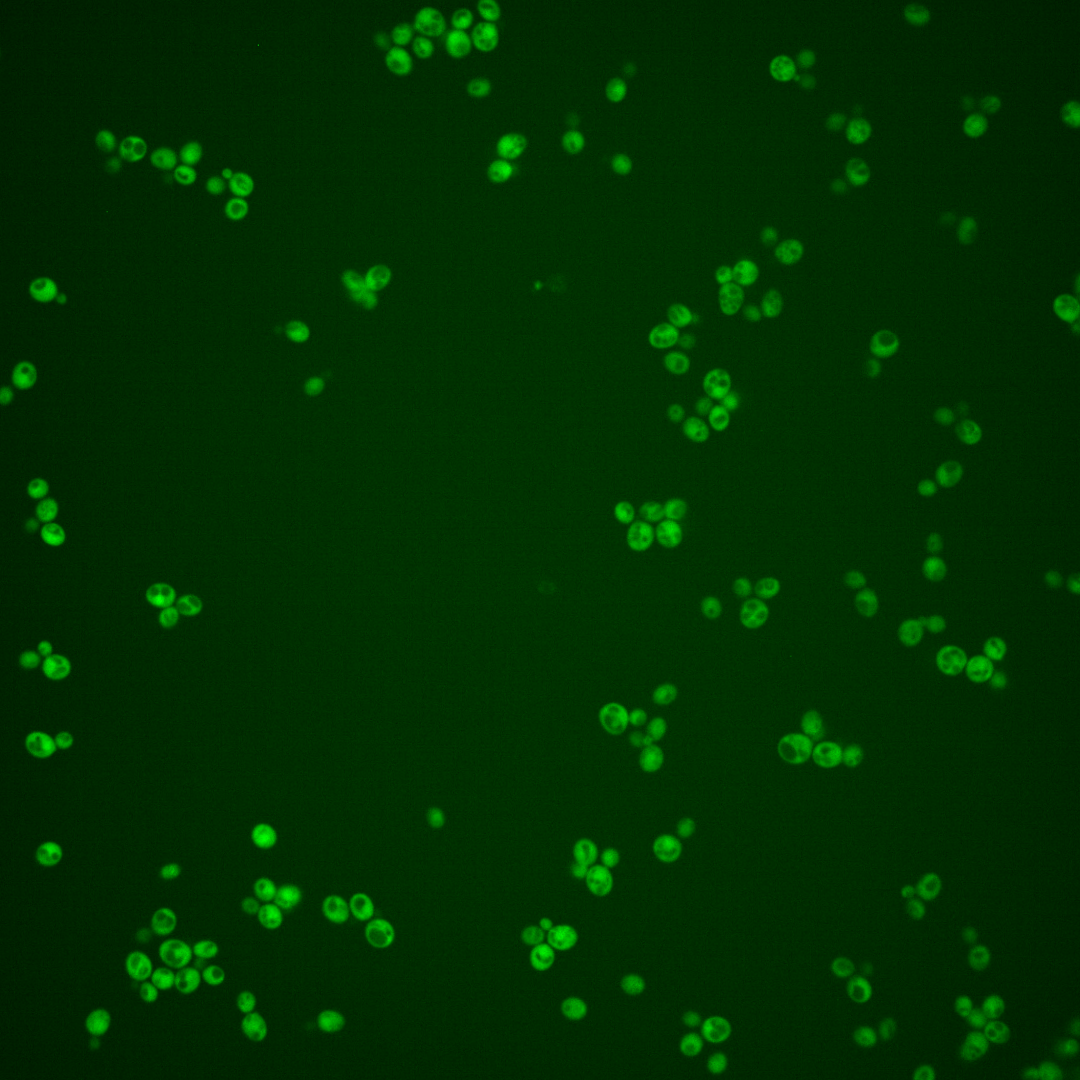
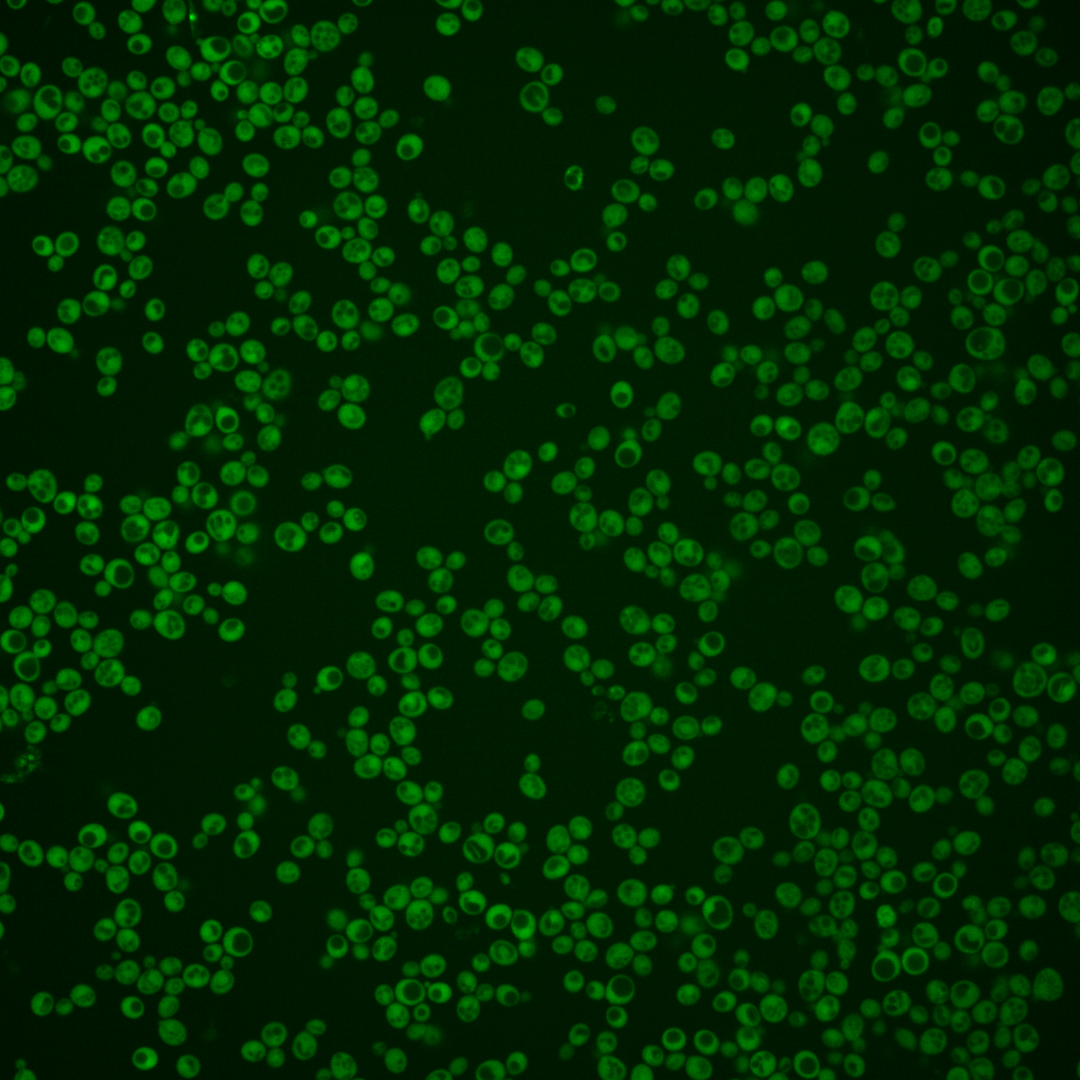
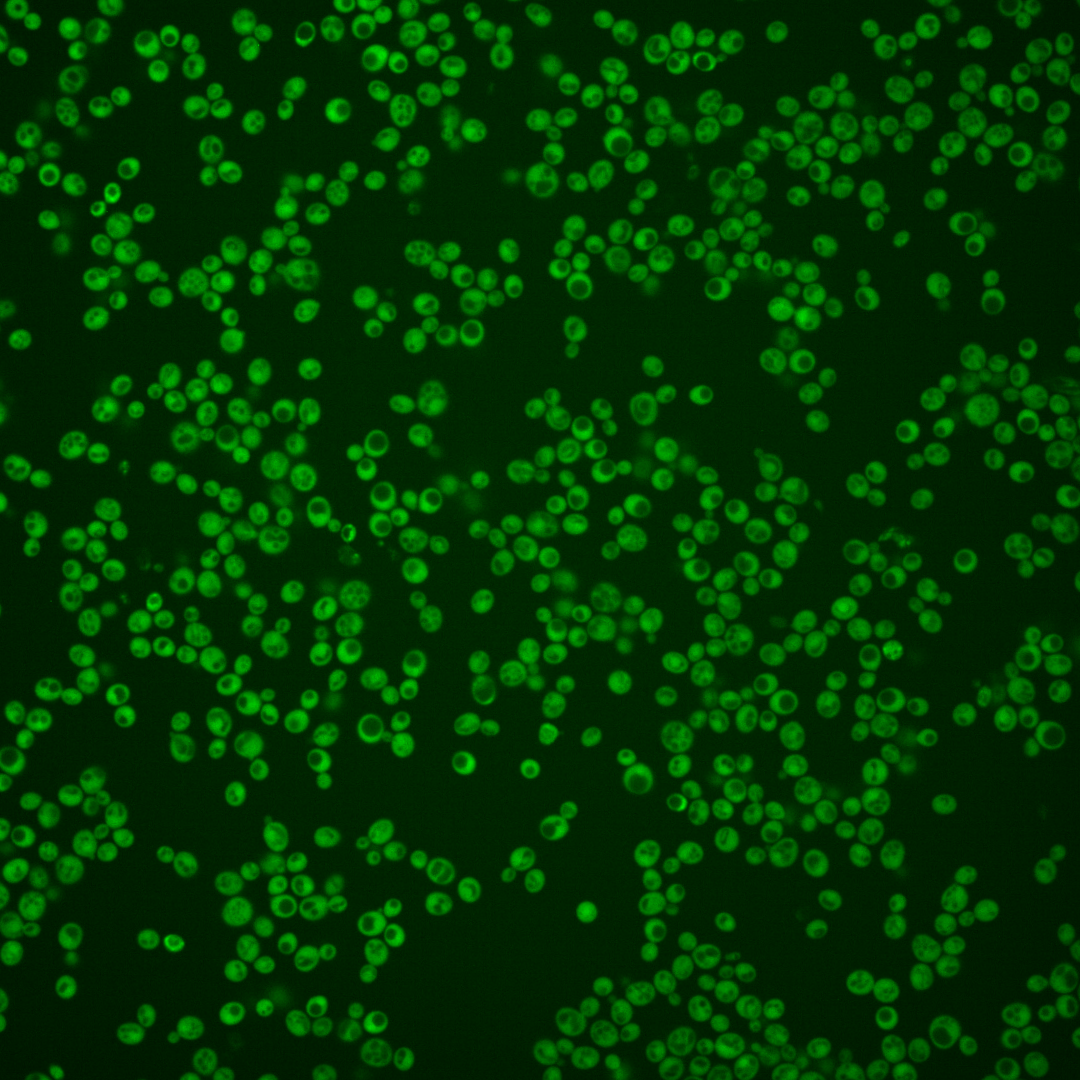
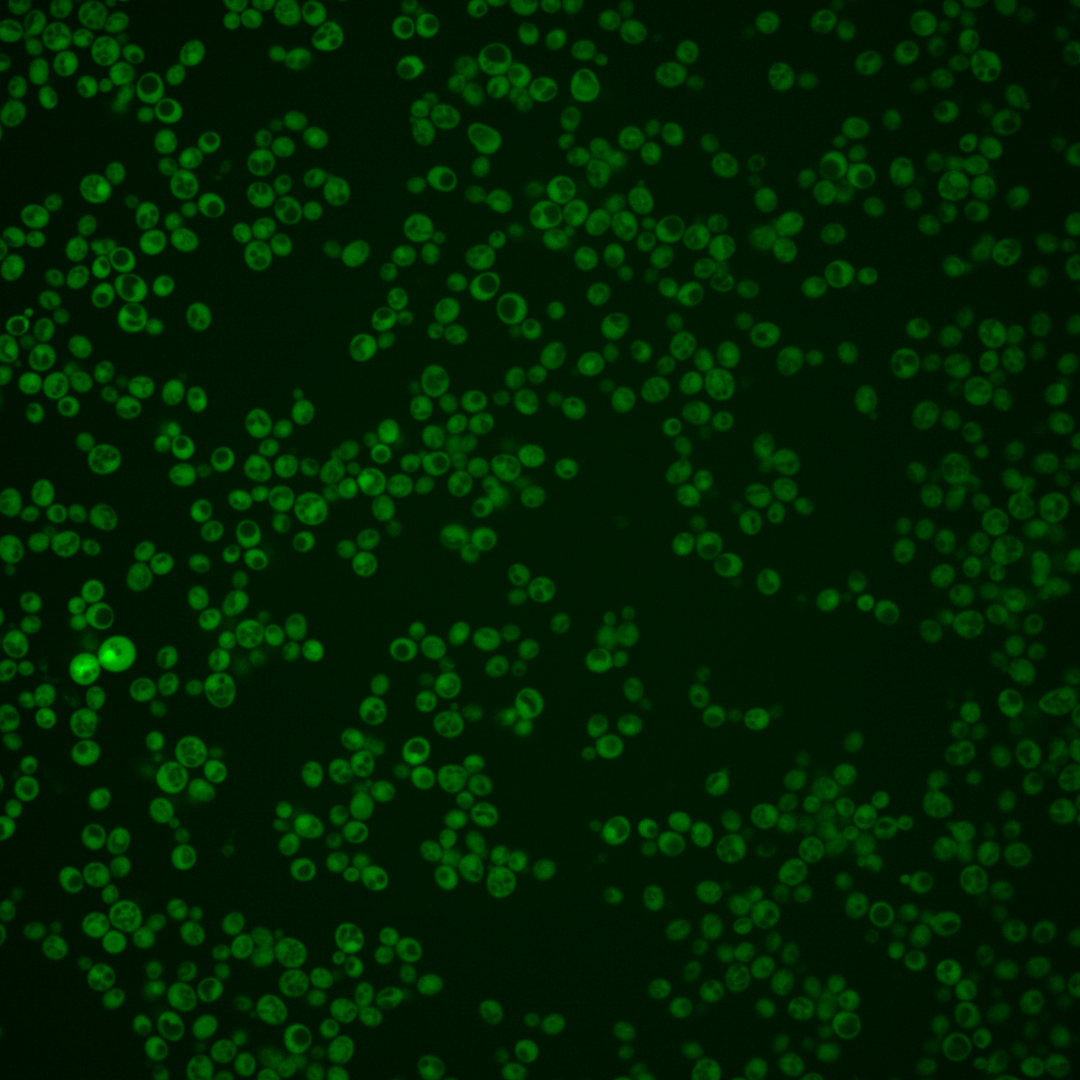

| Standard name | |
|---|---|
| Human Ortholog | |
| Description | Protein of unknown function; required for normal localization of actin patches and for normal tolerance of sodium ions and hydrogen peroxide; localizes to both cytoplasm and nucleus |
Micrographs




















































































Sub-cellular Localization
Yeast GFP Assignment
Protein Abundance
Localization Change
External localization resources
| ensLOC | DeepLoc | |||||||||||||||||||||||
|---|---|---|---|---|---|---|---|---|---|---|---|---|---|---|---|---|---|---|---|---|---|---|---|---|
| Localization | WT1 | WT2 | WT3 | RAP60 | RAP140 | RAP220 | RAP300 | RAP380 | RAP460 | RAP540 | RAP620 | RAP700 | HU80 | HU120 | HU160 | rpd3Δ_1 | rpd3Δ_2 | rpd3Δ_3 | WT1 | WT2 | WT3 | AF100 | AF140 | AF180 |
| Cortical Patches | 0 | 0 | 0 | 0 | 0 | 0 | 0 | 1 | 0 | 0 | 1 | 0 | 0 | 0 | 0 | 0 | 0 | 0 | 0 | 0 | 0 | 0 | 1 | 2 |
| Bud | 1 | 1 | 0 | 0 | 2 | 0 | 1 | 2 | 6 | 6 | 8 | 3 | 0 | 0 | 0 | 0 | 1 | 0 | 0 | 0 | 0 | 0 | 2 | 0 |
| Bud Neck | 0 | 0 | 0 | 0 | 0 | 0 | 0 | 0 | 0 | 0 | 0 | 0 | 0 | 0 | 0 | 0 | 0 | 0 | 0 | 0 | 0 | 0 | 0 | 0 |
| Bud Site | 0 | 0 | 0 | 0 | 0 | 0 | 0 | 0 | 0 | 0 | 0 | 0 | 0 | 0 | 0 | 0 | 0 | 0 | – | – | – | – | – | – |
| Cell Periphery | 0 | 6 | 0 | 4 | 13 | 7 | 16 | 16 | 7 | 12 | 11 | 12 | 3 | 24 | 18 | 29 | 11 | 8 | 0 | 0 | 0 | 0 | 0 | 0 |
| Cytoplasm | 165 | 188 | 94 | 132 | 275 | 197 | 350 | 262 | 157 | 219 | 173 | 164 | 381 | 467 | 490 | 264 | 104 | 156 | 158 | 173 | 110 | 275 | 435 | 350 |
| Endoplasmic Reticulum | 2 | 3 | 1 | 1 | 2 | 0 | 8 | 4 | 3 | 3 | 3 | 1 | 0 | 5 | 2 | 6 | 3 | 3 | 0 | 2 | 0 | 0 | 4 | 4 |
| Endosome | 0 | 0 | 0 | 0 | 0 | 0 | 0 | 0 | 0 | 0 | 0 | 0 | 0 | 0 | 0 | 0 | 0 | 1 | 2 | 0 | 0 | 1 | 2 | 1 |
| Golgi | 1 | 0 | 0 | 0 | 0 | 0 | 0 | 0 | 0 | 0 | 0 | 0 | 0 | 0 | 0 | 0 | 1 | 0 | 2 | 2 | 0 | 0 | 2 | 0 |
| Mitochondria | 3 | 1 | 0 | 0 | 0 | 1 | 23 | 15 | 25 | 19 | 35 | 10 | 1 | 1 | 0 | 0 | 2 | 4 | 2 | 0 | 0 | 0 | 1 | 1 |
| Nucleus | 0 | 2 | 3 | 2 | 3 | 1 | 3 | 4 | 3 | 5 | 2 | 2 | 2 | 0 | 1 | 5 | 1 | 7 | 0 | 1 | 1 | 0 | 0 | 0 |
| Nuclear Periphery | 0 | 0 | 0 | 0 | 0 | 1 | 1 | 0 | 0 | 0 | 0 | 1 | 0 | 0 | 0 | 0 | 0 | 0 | 0 | 0 | 0 | 0 | 0 | 0 |
| Nucleolus | 0 | 0 | 0 | 0 | 0 | 1 | 0 | 0 | 0 | 0 | 0 | 0 | 0 | 0 | 0 | 0 | 0 | 0 | 0 | 0 | 0 | 0 | 0 | 0 |
| Peroxisomes | 0 | 0 | 0 | 0 | 0 | 0 | 0 | 0 | 0 | 0 | 0 | 0 | 0 | 0 | 0 | 0 | 0 | 0 | 0 | 0 | 0 | 0 | 0 | 1 |
| SpindlePole | 0 | 0 | 0 | 0 | 0 | 0 | 0 | 0 | 0 | 0 | 0 | 0 | 0 | 0 | 0 | 0 | 0 | 0 | 0 | 0 | 0 | 0 | 0 | 0 |
| Vac/Vac Membrane | 0 | 0 | 0 | 0 | 0 | 2 | 7 | 8 | 4 | 4 | 3 | 6 | 0 | 0 | 0 | 14 | 1 | 0 | 1 | 1 | 0 | 0 | 0 | 2 |
| Unique Cell Count | 168 | 192 | 96 | 134 | 278 | 201 | 382 | 292 | 184 | 244 | 213 | 183 | 383 | 471 | 491 | 279 | 107 | 162 | 169 | 184 | 115 | 280 | 453 | 368 |
| Labelled Cell Count | 172 | 201 | 98 | 139 | 295 | 210 | 409 | 312 | 205 | 268 | 236 | 199 | 387 | 497 | 511 | 318 | 124 | 179 | 169 | 184 | 115 | 280 | 453 | 368 |
Yeast GFP Assignment
Protein Abundance
| Screen | WT1 | WT2 | WT3 | RAP60 | RAP140 | RAP220 | RAP300 | RAP380 | RAP460 | RAP540 | RAP620 | RAP700 | HU80 | HU120 | HU160 | rpd3Δ_1 | rpd3Δ_2 | rpd3Δ_3 | AF100 | AF140 | AF180 |
|---|---|---|---|---|---|---|---|---|---|---|---|---|---|---|---|---|---|---|---|---|---|
| Mean Cell GFP Intensity (1e-4) | 8.0 | 11.0 | 7.8 | 8.1 | 9.2 | 8.3 | 7.8 | 8.3 | 7.1 | 7.3 | 6.9 | 7.8 | 10.5 | 11.8 | 11.9 | 15.7 | 15.2 | 15.3 | 9.4 | 10.1 | 10.8 |
| Std Deviation (1e-4) | 1.8 | 1.9 | 1.3 | 1.1 | 1.5 | 1.6 | 1.5 | 1.5 | 1.4 | 1.2 | 1.7 | 1.9 | 1.5 | 1.6 | 1.7 | 3.4 | 3.7 | 3.9 | 1.3 | 1.4 | 1.6 |
| Intensity Change (Log2) | – | – | – | 0.05 | 0.23 | 0.09 | 0.0 | 0.09 | -0.14 | -0.1 | -0.18 | -0.01 | 0.43 | 0.59 | 0.61 | 1.0 | 0.96 | 0.97 | 0.27 | 0.37 | 0.46 |
Localization Change
| Localization | RAP60 | RAP140 | RAP220 | RAP300 | RAP380 | RAP460 | RAP540 | RAP620 | RAP700 | HU80 | HU120 | HU160 | rpd3Δ_1 | rpd3Δ_2 | rpd3Δ_3 |
|---|---|---|---|---|---|---|---|---|---|---|---|---|---|---|---|
| Cortical Patches | 0 | 0 | 0 | 0 | 0 | 0 | 0 | 0 | 0 | 0 | 0 | 0 | 0 | 0 | 0 |
| Bud | 0 | 0 | 0 | 0 | 0 | 0 | 0 | 0 | 0 | 0 | 0 | 0 | 0 | 0 | 0 |
| Bud Neck | 0 | 0 | 0 | 0 | 0 | 0 | 0 | 0 | 0 | 0 | 0 | 0 | 0 | 0 | 0 |
| Bud Site | 0 | 0 | 0 | 0 | 0 | 0 | 0 | 0 | 0 | 0 | 0 | 0 | 0 | 0 | 0 |
| Cell Periphery | 0 | 0 | 0 | 0 | 0 | 0 | 0 | 0 | 0 | 0 | 0 | 0 | 3.3 | 3.2 | 0 |
| Cytoplasm | 0.3 | 0.7 | 0.1 | -2.1 | -2.5 | -3.3 | -2.5 | -4.0 | -2.5 | 1.5 | 1.1 | 2.4 | -1.3 | -0.3 | -0.7 |
| Endoplasmic Reticulum | 0 | 0 | 0 | 0 | 0 | 0 | 0 | 0 | 0 | 0 | 0 | 0 | 0 | 0 | 0 |
| Endosome | 0 | 0 | 0 | 0 | 0 | 0 | 0 | 0 | 0 | 0 | 0 | 0 | 0 | 0 | 0 |
| Golgi | 0 | 0 | 0 | 0 | 0 | 0 | 0 | 0 | 0 | 0 | 0 | 0 | 0 | 0 | 0 |
| Mitochondria | 0 | 0 | 0 | 0 | 0 | 3.8 | 2.8 | 4.2 | 0 | 0 | 0 | 0 | 0 | 0 | 0 |
| Nucleus | 0 | 0 | 0 | 0 | 0 | 0 | 0 | 0 | 0 | 0 | 0 | 0 | 0 | 0 | 0 |
| Nuclear Periphery | 0 | 0 | 0 | 0 | 0 | 0 | 0 | 0 | 0 | 0 | 0 | 0 | 0 | 0 | 0 |
| Nucleolus | 0 | 0 | 0 | 0 | 0 | 0 | 0 | 0 | 0 | 0 | 0 | 0 | 0 | 0 | 0 |
| Peroxisomes | 0 | 0 | 0 | 0 | 0 | 0 | 0 | 0 | 0 | 0 | 0 | 0 | 0 | 0 | 0 |
| SpindlePole | 0 | 0 | 0 | 0 | 0 | 0 | 0 | 0 | 0 | 0 | 0 | 0 | 0 | 0 | 0 |
| Vacuole | 0 | 0 | 0 | 0 | 0 | 0 | 0 | 0 | 0 | 0 | 0 | 0 | 0 | 0 | 0 |
External localization resources
Images






























Protein Concentration and Protein Localization Data
| R1 | R2 | R3 | ||||||||||||||||
|---|---|---|---|---|---|---|---|---|---|---|---|---|---|---|---|---|---|---|
| G1 Pre-START | G1 Post-START | S/G2 | Metaphase | Anaphase | Telophase | G1 Pre-START | G1 Post-START | S/G2 | Metaphase | Anaphase | Telophase | G1 Pre-START | G1 Post-START | S/G2 | Metaphase | Anaphase | Telophase | |
| Concentration | 3.2885 | 4.1418 | 3.366 | 3.0927 | 2.9896 | 3.6226 | 3.7837 | 4.6695 | 4.2231 | 3.709 | 3.367 | 4.0911 | 4.4795 | 5.7061 | 4.8788 | 4.5841 | 4.2895 | 5.2898 |
| Actin | 0.0396 | 0.0064 | 0.033 | 0.0098 | 0.04 | 0.0233 | 0.0444 | 0.0012 | 0.0196 | 0.1207 | 0.0849 | 0.0074 | 0.0472 | 0.0037 | 0.0139 | 0.0435 | 0.0187 | 0.0035 |
| Bud | 0.0011 | 0.0014 | 0.0019 | 0.0014 | 0.0006 | 0.0019 | 0.0005 | 0.002 | 0.0008 | 0.0004 | 0.0007 | 0.0036 | 0.0004 | 0.0003 | 0.0074 | 0.0002 | 0.0019 | 0.0023 |
| Bud Neck | 0.0074 | 0.0007 | 0.0077 | 0.0012 | 0.0019 | 0.0018 | 0.0073 | 0.0002 | 0.0011 | 0.0023 | 0.0026 | 0.0021 | 0.0018 | 0.0004 | 0.0007 | 0.0007 | 0.0095 | 0.0014 |
| Bud Periphery | 0.0012 | 0.0004 | 0.0019 | 0.0034 | 0.0014 | 0.0027 | 0.0006 | 0.001 | 0.0017 | 0.0003 | 0.0009 | 0.0034 | 0.0004 | 0.0004 | 0.0011 | 0.0001 | 0.0038 | 0.0014 |
| Bud Site | 0.0156 | 0.014 | 0.0245 | 0.0017 | 0.0018 | 0.0006 | 0.003 | 0.007 | 0.0021 | 0.0017 | 0.0128 | 0.0008 | 0.0038 | 0.0028 | 0.0029 | 0.0005 | 0.0036 | 0.0001 |
| Cell Periphery | 0.0005 | 0.0003 | 0.0014 | 0.0007 | 0.0002 | 0.0002 | 0.0004 | 0.0002 | 0.0003 | 0.0001 | 0.0001 | 0.0001 | 0.0002 | 0.0005 | 0.0001 | 0.0001 | 0.0006 | 0.0007 |
| Cytoplasm | 0.6839 | 0.9147 | 0.7777 | 0.8761 | 0.6709 | 0.8406 | 0.8064 | 0.9417 | 0.882 | 0.7637 | 0.7458 | 0.9182 | 0.8542 | 0.9724 | 0.9457 | 0.938 | 0.8236 | 0.9641 |
| Cytoplasmic Foci | 0.0347 | 0.005 | 0.0243 | 0.0101 | 0.034 | 0.022 | 0.0212 | 0.0019 | 0.0086 | 0.0206 | 0.0197 | 0.0093 | 0.0155 | 0.0027 | 0.0032 | 0.0035 | 0.0364 | 0.003 |
| Eisosomes | 0.0005 | 0 | 0.0003 | 0.0001 | 0.0004 | 0.0001 | 0.0009 | 0 | 0.0001 | 0.0008 | 0.0002 | 0 | 0.0004 | 0 | 0.0001 | 0.0001 | 0.0007 | 0 |
| Endoplasmic Reticulum | 0.007 | 0.0022 | 0.0073 | 0.0082 | 0.0041 | 0.0074 | 0.0038 | 0.0021 | 0.0039 | 0.0031 | 0.0026 | 0.0015 | 0.0046 | 0.0056 | 0.003 | 0.0018 | 0.0066 | 0.0025 |
| Endosome | 0.0418 | 0.001 | 0.0226 | 0.0086 | 0.0232 | 0.0123 | 0.0157 | 0.0007 | 0.014 | 0.0068 | 0.0282 | 0.0035 | 0.0119 | 0.0004 | 0.0023 | 0.0005 | 0.0062 | 0.0068 |
| Golgi | 0.0083 | 0.0004 | 0.0081 | 0.005 | 0.0197 | 0.0053 | 0.0054 | 0.0001 | 0.007 | 0.0144 | 0.0099 | 0.0023 | 0.0066 | 0.0002 | 0.0009 | 0.0007 | 0.0041 | 0.0045 |
| Lipid Particles | 0.0193 | 0.0001 | 0.0076 | 0.0097 | 0.039 | 0.0094 | 0.0093 | 0.0001 | 0.0033 | 0.0181 | 0.0428 | 0.0032 | 0.0066 | 0.0001 | 0.0004 | 0.0001 | 0.0157 | 0.0013 |
| Mitochondria | 0.0182 | 0.0002 | 0.0041 | 0.0085 | 0.005 | 0.0014 | 0.0024 | 0.0001 | 0.0028 | 0.0015 | 0.0037 | 0.0058 | 0.0025 | 0.0001 | 0.0086 | 0.0002 | 0.0241 | 0.0011 |
| None | 0.0599 | 0.0471 | 0.0515 | 0.0302 | 0.0963 | 0.053 | 0.0554 | 0.0392 | 0.0396 | 0.0293 | 0.0037 | 0.0212 | 0.0195 | 0.0062 | 0.0039 | 0.005 | 0.0028 | 0.0028 |
| Nuclear Periphery | 0.0149 | 0.0007 | 0.0031 | 0.0024 | 0.0071 | 0.0043 | 0.0045 | 0.0004 | 0.0012 | 0.0008 | 0.0017 | 0.0005 | 0.0089 | 0.0012 | 0.0009 | 0.0005 | 0.0035 | 0.0009 |
| Nucleolus | 0.0014 | 0.0002 | 0.002 | 0.0001 | 0.0004 | 0.0004 | 0.001 | 0 | 0.002 | 0.0001 | 0.0014 | 0.0001 | 0.0005 | 0 | 0.0002 | 0 | 0.0004 | 0 |
| Nucleus | 0.006 | 0.0032 | 0.0037 | 0.0035 | 0.0019 | 0.0037 | 0.003 | 0.0014 | 0.0032 | 0.001 | 0.002 | 0.0019 | 0.0023 | 0.0019 | 0.0021 | 0.002 | 0.0062 | 0.0016 |
| Peroxisomes | 0.02 | 0.0002 | 0.0085 | 0.0143 | 0.0418 | 0.0028 | 0.0077 | 0 | 0.0035 | 0.012 | 0.026 | 0.0127 | 0.0055 | 0.0001 | 0.0008 | 0.0019 | 0.0187 | 0.0007 |
| Punctate Nuclear | 0.0137 | 0.001 | 0.0054 | 0.0018 | 0.0079 | 0.0048 | 0.0052 | 0.0003 | 0.0009 | 0.0018 | 0.0084 | 0.002 | 0.0056 | 0.0005 | 0.0016 | 0.0003 | 0.0074 | 0.0005 |
| Vacuole | 0.0033 | 0.0008 | 0.0027 | 0.0029 | 0.0012 | 0.0015 | 0.0012 | 0.0004 | 0.0019 | 0.0003 | 0.0015 | 0.0004 | 0.0007 | 0.0004 | 0.0004 | 0.0003 | 0.0047 | 0.0006 |
| Vacuole Periphery | 0.0016 | 0.0001 | 0.0007 | 0.0006 | 0.0012 | 0.0005 | 0.0005 | 0 | 0.0004 | 0.0002 | 0.0005 | 0.0001 | 0.0007 | 0 | 0.0001 | 0 | 0.0009 | 0.0002 |
Sequencing Data
| R1 | R2 | |||||||||
|---|---|---|---|---|---|---|---|---|---|---|
| G1 Post-START | S/G2 | Metaphase | Anaphase | Telophase | G1 Post-START | S/G2 | Metaphase | Anaphase | Telophase | |
| Gene Expression | 33.6475 | 41.488 | 46.9484 | 56.4975 | 50.3949 | 49.8634 | 50.3381 | 56.9786 | 66.8742 | 50.5817 |
| Translational Efficiency | 1.4936 | 1.1226 | 1.0341 | 0.8461 | 0.8958 | 1.3845 | 1.0373 | 1.0055 | 0.9122 | 0.978 |
Hit Data
| Dataset | Hit |
|---|---|
| Protein Concentration | ✘ |
| Protein Localization | ✘ |
| Gene Expression | ✘ |
| Translational Efficiency | ✘ |
Endocytosis
| Temp | Actin Patch (Sac6-tdTomato) | Cortical Patch (Sla1-GFP) | Late Endosome (Snf7-GFP) | Vacuole (Vph1-GFP) |
|---|---|---|---|---|
| 37℃ | ||||
| RT |
Cell Cycle Omics
CYCLoPs (Apd1-GFP)
| Gene / Allele | Actin Patch (Sac6-tdTomato) | Cortical Patch (Sla1-GFP) | Late Endosome (Snf7-GFP) | Vacuole (Sac6-tdTomato) |
|---|
| Gene | Images |
|---|
| Gene | Images |
|---|
Images are not yet available
Images are not yet available